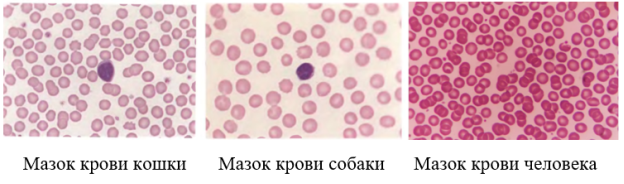
Визуальное сравнение эритроцитов кошки, собаки и человека
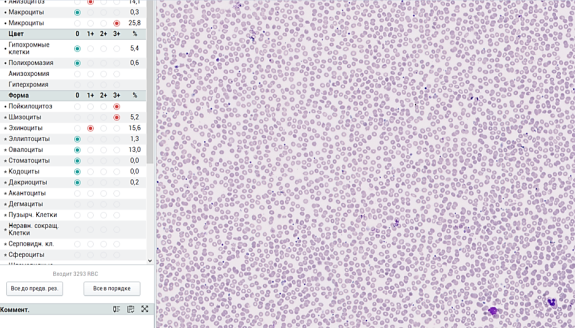
Мазок крови человека в изображении лабораторной информационной системы
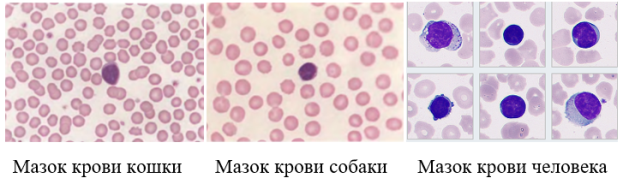
Визуальное сравнение лейкоцитов
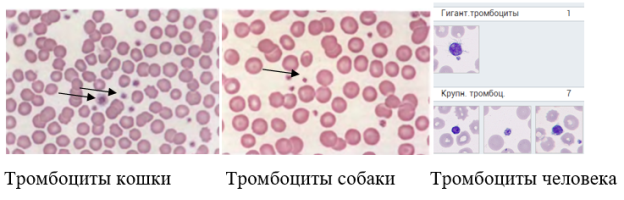
Визуальное сравнение тромбоцитов кошки, собаки и человека

Кровь (sanguis; греч. haima) — это жидкая ткань, циркулирующая по сосудам, осуществляющая транспорт различных веществ в пределах организма и обеспечивающаяпитание и обмен веществ всех клеток тела [1]. Гемоглобин, содержащийся в эритроцитах, придает крови красный цвет. Учение о крови и ее болезнях называется гематологией. У человека количество крови составляет 1/13 его массы, т. е. у взрослого примерно — 5–6 л, у подростка — 3 л [1].
Если взятую у человека или животного кровь поместить в сухую пробирку и, предохранив от свертывания, обеспечить возможность ее отстаивания, то она разделится на два слоя. Сверху будет слой, состоящий из прозрачной светло-желтой жидкости — плазмы (составляет около 55 %объема крови), а снизу — осадок из клеток крови (рис. 1).
![Компоненты крови [2]](https://articles-static-cdn.moluch.org/articles/y/5547/images/5547-1.png)
Рис. 1. Компоненты крови [2]
В плазму крови входит множество простых и сложных веществ. Девяносто процентов плазмы составляет вода и только ее десять процентов приходится на сухой остаток из белков (альбумины, глобулины и фибриноген), жиров, углеводов, металлов, всех элементов таблицы Д. И. Менделеева, солей, щелочей, кислот, различных газов, витаминов, ферментов и гормонов. Каждое из этих веществ имеет определенное значение. Белки являются «строительным материалом» организма, жиры и углеводы — источником энергии. Соли, щелочии кислоты поддерживают постоянство внутренней среды, изменение которой опасно дляжизни. Ферменты, витамины и гормоны обеспечивают правильный обмен веществ в организме, его рост, развитие и взаимное влияние органов и систем [1].
Что же представляют собой клетки — форменные элементы крови? Это красные кровяные тельца — эритроциты, белые кровяные тельца — лейкоциты и кровяные пластинки — тромбоциты (рис. 2).
![Форменные элементы крови [2]](https://articles-static-cdn.moluch.org/articles/y/5547/images/5547-2.png)
Рис. 2. Форменные элементы крови [2]
В понятие «система крови» включается кровь, органы кроветворения (красный костный мозг, лимфатические узлы), органы кроворазрушения и механизмы регуляции. Система крови — одна из важнейших систем жизнеобеспечения организма и выполняет множество функций. Остановка сердца и прекращение движения крови немедленно приводит организм к гибели [1].
Система крови (или кровеносная система) обеспечивает постоянство внутренней среды организма (гомеостаз), перенос кислорода и углекислого газа в организме, питательных веществ, конечных вредных продуктов обмена, обмен веществ между кровью и тканями, терморегуляцию, иммунную защиту организма (перенос антител), участвует в процессах восстановления (регенерации) тканей.
Общий анализ крови, который также называют клиническим, — базовое исследование, которое проводится для оценки общего состояния человека или животного, первичной диагностики некоторых состояний, например, анемий, обезвоживания, воспалительных процессов, инфекций. Расшифровка общего анализа крови не указывает на конкретные заболевания. Для этого применяются дополнительные лабораторные и инструментальные методы обследования, но может обозначаться направление, в котором необходимо проводить дальнейшие исследования.
При общем анализе крови определяются показатели так называемой «красной» и «белой» крови. К «красной» крови относятся элементы, отвечающие за перенос кислорода — эритроциты, гемоглобин, связанные с ними показатели — гематокрит, СОЭ (скорость оседания эритроцитов), а также тромбоциты, участвующие в процессе свертывания. «Белая» кровь — это белые кровяные тельца, или лейкоциты, которые дополнительно разделяются на лимфоциты, моноциты, нейтрофилы, эозинофилы, базофилы.
Рассматриваются функции, которые выполняют основные клетки крови организма. Эритроциты, красные кровяные тельца, отвечают за перенос кислорода и некоторых других веществ к тканям, за счет чего осуществляется их питание. Тромбоциты участвуют в образовании тромбов (сгустков крови), которые в норме необходимы для остановки кровотечения. Лейкоциты, белые клетки крови, отвечают за иммунитет и способность организма противостоять инфекциям, другим внешним и внутренним воздействиям (аллергенам, паразитам и пр.).
Изучались основные клетки крови на базе крупной частной клинико-диагностической лаборатории в Москве при участии внешнего эксперта — врач КДЛ, кандидат медицинских наук Фадеева Ирина Анатольевна. Использовались обезличенные пронумерованные остаточные образцы крови человека. Для тестирования образцов применялся автоматический гематологический анализатор Mindray BC-6800 Plus, встроенный в роботизированную линию гематологических анализаторов (рис. 3).

Рис. 3. Роботизированная линия гематологических анализаторов
Анализатор BC-6800Plus позволяет протестировать 200 проб крови за один час, может сохранять результаты ста тысяч исследований, окрашивает клетки крови и микроскопирует их. В случае обнаружения отклонения от нормы анализатор флагирует (буквально выставляет красный флаг в специальном программном обеспечении) на патологическом результате и предупреждает врача КДЛ особым информационным сообщением (рис.4).

Рис. 4. Сообщение от лабораторной информационной системы о выявленном отклонении от нормы в анализе крови
Если прибор выявил отклонение от нормы и «поставил красный флаг», то врач дополнительно просматривает такие пробы с помощью микроскопа.
В исследовании использовалась кровь домашних питомцев (кота Тиши (6 лет) и собаки Майка (2 года)) (рис. 5) для определения нормальных (референсных) ее показателей у этих млекопитающих.

Рис. 5. Собака Майк и кот Тиша
Картины крови животных сравнивались с остаточными образцами крови человека, имеющимися в лаборатории. Также использовались результаты, приведенные в литературных источниках [1] — [5]. Визуальное сравнение эритроцитов млекопитающих и человекапредставлено на рис.6.
Рис.6. Визуальное сравнение эритроцитов кошки, собаки и человека
При рассматривании эритроцитов человека и животных отмечено следующее. Эритроциты животных и человека внешне очень похожи: округлые, с зоной просветления в центре и без ядра. Эритроциты кошки — меньше по размеру, чем у собаки, а эритроциты собаки и человека — почти одного размера. Так же видно, что эритроциты кошки различаются по размеру между собой, почти не имеют светлого пятна (зоны просветления) в центре. Эритроциты собаки одинаковы по размеру и имеют выраженную зону просветления. Эта зона наиболее выражена у эритроцитов человека. Также у человека наблюдается высокая плотность этих клеток в мазке.
Результаты наблюдений подтверждаются соответствующими литературными данными, представленными в таблице 1.
Таблица 1
Основные параметры сравнения эритроцитов
|
Параметры сравнения |
Человек |
Собака |
Кошка |
|
Диаметр эритроцита, мкм |
7,8 |
7 |
5 |
|
Ядро |
отсутствует |
отсутствует |
отсутствует |
|
Зона просветления |
+++ |
++ |
+ |
На рис. 7 показаны результаты измерения клеток крови человека с использованием лабораторной информационной системы.
Рис. 7. Мазок крови человека в изображении лабораторной информационной системы
В представленном мазке крови человека основная форма эритроцитов — округлая. В центре — выраженная зона просветления. Ядро отсутствует.
Лейкоциты (греческое leukos — белый, kytos — вместилище) — элементы «белой крови», одна из трех разновидностей форменных элементов крови позвоночных животных и человека [1]. Лейкоциты млекопитающих представлены множеством клеток, различных по форме, размеру, а также по форме и количеству ядер. Например, лимфоциты являются основными клетками иммунной системы лейкоцитарного ростка. Они обеспечивают специфический иммунитет (иммунитет против определенных болезней — гриппа, ветрянки, кори и пр.), синтезируют иммуноглобулины (антитела), уничтожают собственные мутировавшие клетки (рис.8).
При визуальном изучении мазков крови кошки, собаки и человека отмечается большое сходство лейкоцитарных клеток (в данном случае лимфоцитов). При этом лимфоциты человека могут очень сильно различаться между собой по размеру и форме ядра. Некоторые лимфоциты по размеру схожи с эритроцитом (не превышают 6–7 мкм), некоторые — очень большие (диаметр больше в 2–2,5 раза). Лимфоциты кошки и собаки очень близки по размеру к эритроцитам. При этом общим свойством лимфоцитов всех животных является большое ядро, которое занимает почти всю цитоплазму клетки.
Рис. 8. Визуальное сравнение лейкоцитов
В таблице 2, составленной на основании изучения литературных источников, можно заметить подтверждение визуальных наблюдений о размере и строении лимфоцитов.
Таблица 2
Основные параметры сравнения лейкоцитов
|
Параметры сравнения |
Человек |
Собака |
Кошка |
|
Диаметр лейкоцита (лимфоцита), мкм |
от 6 до 15 |
от 6 до 8 |
от 6 до 10 |
|
Ядро |
большое, заполняет всю цитоплазму |
большое, заполняет всю цитоплазму |
большое, заполняет всю цитоплазму |
На рис.9 показан пример значительной вариабельности формы лейкоцитов человека и, в частности, лимфоцитов.
Тромбоциты животных и человека очень похожи, что можно видеть на рис. 10. Тромбоциты представляют собой маленькие, безъядерные, дисковидные клетки, которые содержат мелкие, розовые или пурпурные зерна в цитоплазме [1].

Рис. 9. Лейкоциты человека в изображении лабораторной информационной системы
Их диаметр обычно составляет от 2 до 4 мкм. Иногда в момент сбора крови у тромбоцитов появляются маленькие выступы. Этот процесс называется активацией тромбоцитов [5].
Рис. 10. Визуальное сравнение тромбоцитов кошки, собаки и человека
В таблице 3 представлены основные параметры сравнения тромбоцитов.
Таблица 3
Основные параметры сравнения тромбоцитов
|
Параметры сравнения |
Человек |
Собака |
Кошка |
|
Диаметр тромбоцита, мкм |
от 2 до 3 |
от 2 до 4 |
от 3 до 5 |
|
Ядро |
отсутствует |
отсутствует |
отсутствует |
|
Гранулы (зерна) в цитоплазме |
наблюдаются |
наблюдаются |
наблюдаются |
Сравнение нормальных (референсных) значений показателей кровикошки, собаки и человека по основным показателям представлены в таблице 4. Цифры в таблице обозначают количество клеток в литре.
Таблица 4
Сравнение нормальных значений показателей крови
|
Показатель |
Взрослые кошки |
Взрослые собаки |
Взрослые мужчины |
Взрослые женщины |
|
Эритроциты, ×10 12 / л |
от 5,6 до 10,1 |
от 5,3 до 8,4 |
от 4,3 до 5,7 |
от 3,8 до 5,1 |
|
Лейкоциты, ×10 9 / л |
от 6,5 до 18,5 |
от 8,5 до 10,5 |
от 4 до 10 | |
|
Тромбоциты, ×10 9 / л |
от 300 до 700 |
от 250 до 550 |
от 150 до 400 | |
Следует отметить, что современный гематологический анализатор минимизирует участие специалиста в процессе обработки клеток крови, что позволяет практически полностью исключить влияние человеческого фактора, снизить количество возможных ошибок. Кроме того, прибор значительно ускоряет выполнение исследования. Это становится важным в случае необходимости оперативного определения диагноза.
По результатам выполненного исследования можно сделать следующие выводы:
- Выявлено, что наиболее сильная центральная бледность эритроцитов наблюдается в крови человека, у млекопитающих с более мелкими эритроцитами, таких как кошки, эритроциты менее вогнуты, поэтому центральная бледность почти незаметна.
- Сравнение тромбоцитов показало, что у кошек они сильно различаются по размеру.
- В крови собак выявлен большой разброс нормальных показателей лимфоцитов.
- Отмечено, что кровь человека внешне более схожа с кровью собак, чем с кровью кошек.
- Установлено соответствие результатов визуальных наблюдений и имеющимися литературными данными.
Литература:
- Щербатова Т. В. Кровь: состав и функции — Текст: электронный // Новороссийский медицинский колледж: [сайт]. — URL: https://www.novorosmk.ru/zanyatiya/krov-sostav-i-funktsii
- Кровь. Что это такое? — Текст: электронный //Тамбовское областное государственное бюджетное учреждение здравоохранения «Городская больница им. С. С. Брюхоненко г. Мичуринска»: [сайт]. — URL: https://ngradlpu.ru/children/-/asset_publisher
- Луговская С. А., Почтарь М. Е. Гематологический атлас. — М.: Триада, 2016. 368 с.
- Сандерс Т. Г., Риган В. Д., Деникола Д. Б. Атлас ветеринарной гематологии. — М.: Аквариум, 2014. 136 с.
- Мирошников М. В. Вариабельность гематологических параметров и установление их референтных интервалов в доклинических исследованиях. Сообщение 2: хищники. — Текст: электронный // Лабораторные животные для научных исследований: [сайт]. — URL: https://labanimalsjournal.ru/ru/2618723x-2025–01–02

